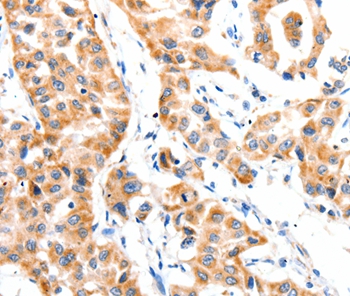
Anti-PAFAH1B1 Antibody

Immunohistochemistry analysis in human testis and liver tissues using HPA020036 antibody. Corresponding PAFAH1B1 RNA-seq data are presented for the same tissues.
Anti-PAFAH1B1 Antibody
HPA020036
ApplicationsImmunoCytoChemistry, ImmunoHistoChemistry
Product group Antibodies
ReactivityHuman
TargetPAFAH1B1
Overview
- SupplierAtlas Antibodies
- Product NameAnti-PAFAH1B1 Antibody
- Delivery Days Customer4
- ApplicationsImmunoCytoChemistry, ImmunoHistoChemistry
- CertificationResearch Use Only
- ClonalityPolyclonal
- ConjugateUnconjugated
- Gene ID5048
- Target namePAFAH1B1
- Target descriptionplatelet activating factor acetylhydrolase 1b regulatory subunit 1
- Target synonymsLIS1, LIS2, MDCR, MDS, NudF, PAFAH, platelet-activating factor acetylhydrolase IB subunit beta, lissencephaly 1 protein, platelet-activating factor acetylhydrolase 1b, regulatory subunit 1 (45kDa)
- HostRabbit
- IsotypeIgG
- Protein IDP43034
- Protein NamePlatelet-activating factor acetylhydrolase IB subunit beta
- Scientific DescriptionRecombinant Protein Epitope Signature Tag (PrEST) antigen sequence
- ReactivityHuman
- Storage Instruction-20°C,2°C to 8°C
- UNSPSC41116161